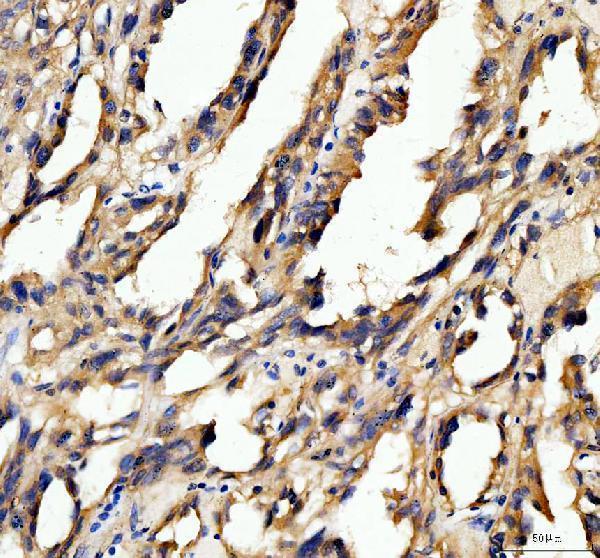
dz33984 prdx primary antibodies ihc testing 4

Product Info Summary
| SKU: | DZ33984 |
|---|---|
| Size: | 200 μl/vial |
| Reactive Species: | Human, Mouse, Rat |
| Host: | Rabbit |
| Application: | IHC, WB |
Customers Who Bought This Also Bought
Product info
Product Name
Anti-human peroxidasin homolog isoform X1 Antibody
SKU/Catalog Number
DZ33984
Size
200 μl/vial
Form
Liquid
Description
Boster Bio Anti-peroxidasin homolog isoform X1 Antibody catalog # DZ33984. Tested in IHC-P, WB applications. This antibody reacts with human, mouse, rat.
Storage & Handling
At -20°C for one year, at 4°C for one month. Avoid repeated freezing and thawing.
Cite This Product
Anti-human peroxidasin homolog isoform X1 Antibody (Boster Biological Technology, Pleasanton CA, USA, Catalog # DZ33984)
Host
Rabbit
Contents
Each vial contains 20mM PBS, 50% glycerol, 0.02% NaN3.
Clonality
Polyclonal
Isotype
Rabbit IgG
Reactive Species
DZ33984 is reactive to PXDN in Human, Mouse, Rat
Calculated molecular weight
165.3 kDa
Application & Images
Applications
DZ33984 is guaranteed for IHC, WB Boster Guarantee
Assay Dilutions Recommendation
The recommendations below provide a starting point for assay optimization. The actual working concentration varies and should be decided by the user.
Western blot, 0.5 μg/ml, Hu, Ms, Rat
Immunohistochemistry(Paraffin-embedded Section), 1 μg/ml, Hu
Positive Control
WB: human Hela whole cell, human U251 whole cell, rat heart tissue, mouse heart tissue
IHC: human pancrease cancer tissue, human renal cancer tissue
Validation Images & Assay Conditions

Click image to see more details
Western blot analysis of Peroxidasin homolog isoform X1 using anti-Peroxidasin homolog isoform X1 antibody (DZ33984).
Electrophoresis was performed on a 5-20% SDS-PAGE gel at 70V (Stacking gel) / 90V (Resolving gel) for 2-3 hours. The sample well of each lane was loaded with 50ug of sample under reducing conditions.
Lane 1: human Hela whole cell lysates,
Lane 2: human U251 whole cell lysates,
Lane 3: rat heart tissuel lysates,
Lane 4: mouse heart tissuel lysates.
After Electrophoresis, proteins were transferred to a Nitrocellulose membrane at 150mA for 50-90 minutes. Blocked the membrane with 5% Non-fat Milk/ TBS for 1.5 hour at RT. The membrane was incubated with rabbit anti-Peroxidasin homolog isoform X1 antigen affinity purified polyclonal antibody (Catalog # DZ33984) at 0.5 μg/mL overnight at 4°C, then washed with TBS-0.1%Tween 3 times with 5 minutes each and probed with a goat anti-rabbit IgG-HRP secondary antibody at a dilution of 1:10000 for 1.5 hour at RT. The signal is developed using an Enhanced Chemiluminescent detection (ECL) kit (Catalog # EK1002) with Tanon 5200 system. A specific band was detected for Peroxidasin homolog isoform X1 at approximately 165 kDa.

Click image to see more details
IHC analysis of Peroxidasin homolog isoform X1 using anti-Peroxidasin homolog isoform X1 antibody (DZ33984).
Peroxidasin homolog isoform X1 was detected in paraffin-embedded section of human pancrease cancer tissue. Heat mediated antigen retrieval was performed in EDTA buffer (pH8.0, epitope retrieval solution). The tissue section was blocked with 10% goat serum. The tissue section was then incubated with 1μg/ml rabbit anti-Peroxidasin homolog isoform X1 Antibody (DZ33984) overnight at 4°C. Biotinylated goat anti-rabbit IgG was used as secondary antibody and incubated for 30 minutes at 37°C. The tissue section was developed using Strepavidin-Biotin-Complex (SABC) (Catalog # SA1022) with DAB as the chromogen.

Click image to see more details
IHC analysis of Peroxidasin homolog isoform X1 using anti-Peroxidasin homolog isoform X1 antibody (DZ33984).
Peroxidasin homolog isoform X1 was detected in paraffin-embedded section of human renal cancer tissue. Heat mediated antigen retrieval was performed in EDTA buffer (pH8.0, epitope retrieval solution). The tissue section was blocked with 10% goat serum. The tissue section was then incubated with 1μg/ml rabbit anti-Peroxidasin homolog isoform X1 Antibody (DZ33984) overnight at 4°C. Biotinylated goat anti-rabbit IgG was used as secondary antibody and incubated for 30 minutes at 37°C. The tissue section was developed using Strepavidin-Biotin-Complex (SABC) (Catalog # SA1022) with DAB as the chromogen.
Click image to see more details
IHC analysis of Peroxidasin homolog isoform X1 using anti-Peroxidasin homolog isoform X1 antibody (DZ33984).
Peroxidasin homolog isoform X1 was detected in paraffin-embedded section of human renal cancer tissue. Heat mediated antigen retrieval was performed in EDTA buffer (pH8.0, epitope retrieval solution). The tissue section was blocked with 10% goat serum. The tissue section was then incubated with 1μg/ml rabbit anti-Peroxidasin homolog isoform X1 Antibody (DZ33984) overnight at 4°C. Biotinylated goat anti-rabbit IgG was used as secondary antibody and incubated for 30 minutes at 37°C. The tissue section was developed using Strepavidin-Biotin-Complex (SABC) (Catalog # SA1022) with DAB as the chromogen.
Specific Publications For Anti-human peroxidasin homolog isoform X1 Antibody (DZ33984)
Loading publications
Recommended Resources
Here are featured tools and databases that you might find useful.
- Boster's Pathways Library
- Protein Databases
- Bioscience Research Protocol Resources
- Data Processing & Analysis Software
- Photo Editing Software
- Scientific Literature Resources
- Research Paper Management Tools
- Molecular Biology Software
- Primer Design Tools
- Bioinformatics Tools
- Phylogenetic Tree Analysis
Customer Reviews
Have you used Anti-human peroxidasin homolog isoform X1 Antibody?
Share your experimental results or join a short interview to earn up to $1,000 in product credits or other rewards.
0 Reviews For Anti-human peroxidasin homolog isoform X1 Antibody
Customer Q&As
Have a question?
Find answers in Q&As, reviews.
Can't find your answer?
Submit your question




